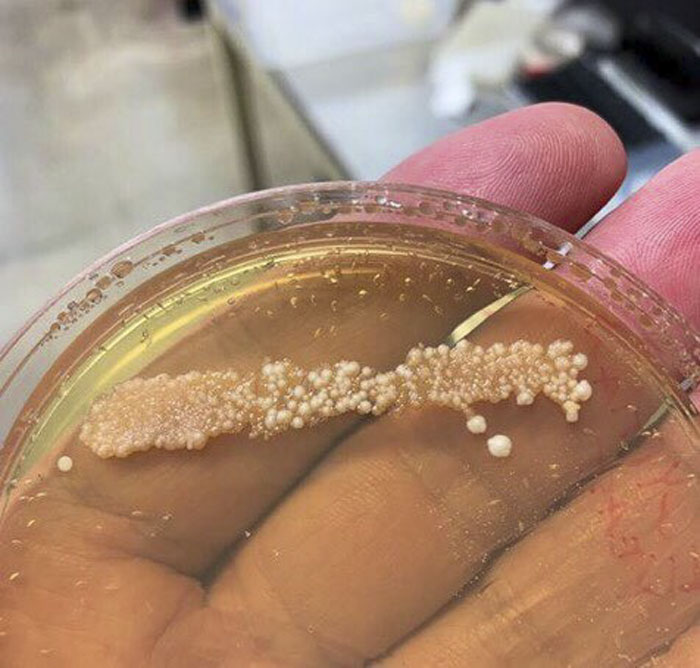
Scientist Bakes Bread From 4,500-Year-Old Yeast, Says The Flavor Is Incredible Scientist Bakes Bread From 4,500-Year-Old Yeast, Says The Flavor Is Incredible
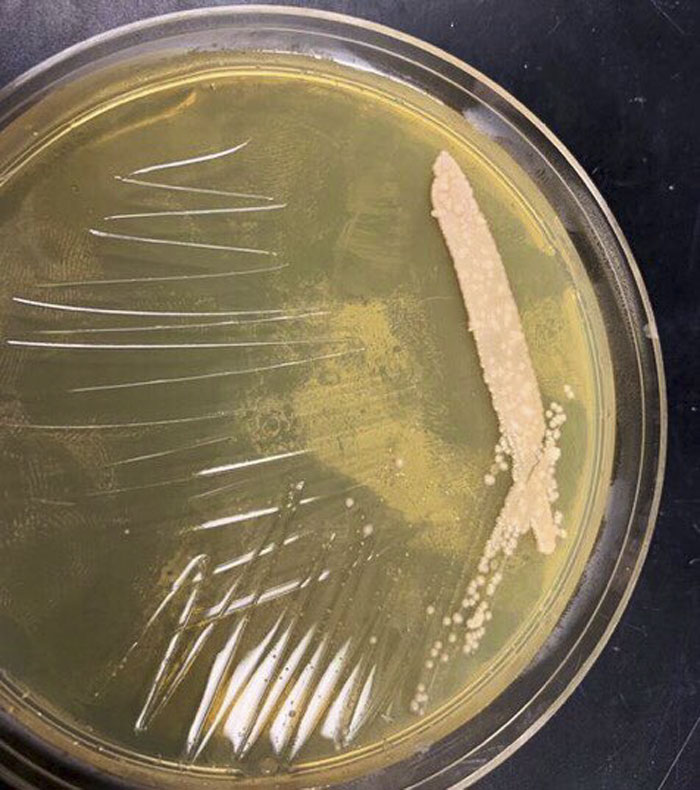
Scientist Bakes Bread From 4,500-Year-Old Yeast, Says The Flavor Is Incredible Scientist Bakes Bread From 4,500-Year-Old Yeast, Says The Flavor Is Incredible

Scientist Bakes Bread From 4,500-Year-Old Yeast, Says The Flavor Is Incredible
Bread, bread, glorious bread. You can dunk it in delicious sauces. Spread cheese on it. Toast it. Or eat it all by itself. There’s nothing like a warm roll on a crisp British morning or a fresh baguette (or two) while watching the sun rise above the Seine. You can practically hear English sheep bleating and French accordions playing as you’re reading this. Who doesn’t love bread, the food staple that’s been around since the dawn of civilization? And don’t even get me started on pastries.
One man who is head-over-heels in love with baking is Seamus Blackley, a scientist who used 4,500-year-old yeast to bake a loaf of bread. That’s as cool as it looks delicious! It seems like doing this project was one of the happiest moments in the scientist’s entire life. Fun fact: Blackley is known far and wide as the father of the Xbox. From baking to consoles, talk about the 21st century’s Leonardo da Vinci.
More info: Twitter
Seamus Blackley collected ancient yeast samples from 4,500-year-old Egyptian pottery
Image credits: Seamus Blackley
Image credits: Seamus Blackley
Image credits: Seamus Blackley
Image credits: Seamus Blackley
Blackley posted on Twitter how he, together with a pair of scientists (an Egyptologist and a microbiologist), collected yeast from 4,500-year-old Egyptian pottery. They took samples from containers they suspected were used for bread-making and beer-brewing in Ancient Egypt. Blackley kept a single sample of the antique yeast and used milled barley, as well as Einkorn flour to ‘awaken’ the yeast. After a week’s worth of patient waiting, the scientist was ready to start baking!
Bored Panda interviewed Dr. Serena Love, Honorary Research Fellow in Archaeology at the University of Queensland, and one of the scientists working together with Blackley: “Seamus wanted ancient yeast to bake bread with and I want to brew beer with it. I got us access to museum collections and Seamus collected some samples in late July. We’ve been working on this since May.”
Dr. Love also told Bored Panda that she’ll “get to taste the bread tomorrow! Pretty excited! Brewing beer is next.”
Image credits: Seamus Blackley
Image credits: Seamus Blackley
Image credits: Seamus Blackley
The father of the Xbox tried to use the same ingredients that Ancient Egyptians would have used for bread-baking and described the smell of the 4,500-year-old yeast, and the bread as something different from what we’re used to: “The crumb is light and airy, especially for a 100% ancient grain loaf. The aroma and flavor are incredible. I’m emotional. It’s really different, and you can easily tell even if you’re not a bread nerd. This is incredibly exciting, and I’m so amazed that it worked.”
Image credits: Seamus Blackley
Image credits: Seamus Blackley
Image credits: Seamus Blackley
Blackley’s gastronomic excitement is understandable. Scientists have been experimenting with ancient food cultures for quite some time now. For example, in May 2019, scientists from Israel’s Hebrew University of Jerusalem brewed beer from 5,000-year-old yeast, found on pottery shards that were used as beer jugs in times barely-remembered.
Blackley ‘fed’ the yeast with barley and Einkorn flour
Image credits: Seamus Blackley
Image credits: Seamus Blackley
Image credits: Seamus Blackley
Image credits: Seamus Blackley
Image credits: Seamus Blackley
It’s no surprise that Blackley used yeast cultures found in Ancient Egyptian pottery — it was their MVP. Egyptians loved bread, and made it their staple: people of all classes and creeds would eat bread at every meal. Would you be willing to try Blackley’s antique bread recipe? How different do you think bread with Ancient Egyptian yeast is likely to be from store-bought loaves? Let us know in the comments below, while I go get myself a baguette and some cheese.
After waiting for a week, it was time to get baking!
Image credits: Seamus Blackley
Image credits: Seamus Blackley
Image credits: Seamus Blackley
The scientist used the same ingredients Ancient Egyptians used for their bread
Image credits: Seamus Blackley
Image credits: Seamus Blackley
Image credits: Seamus Blackley
Image credits: Seamus Blackley
Image credits: Seamus Blackley
Image credits: Seamus Blackley
Image credits: Seamus Blackley
Image credits: Seamus Blackley
Blackley was extremely happy his project was a success — his bread looked absolutely ravishing!
Image credits: Seamus Blackley
Image credits: Seamus Blackley
Image credits: Seamus Blackley
Image credits: Seamus Blackley
Image credits: Seamus Blackley
Image credits: Seamus Blackley
Image credits: Seamus Blackley
Image credits: Seamus Blackley
Image credits: Seamus Blackley
Image credits: Seamus Blackley
Image credits: socalbio.org
People loved Blackley’s idea to bake antique bread and kept making Ancient Egyptian jokes
Image credits: DavidWe91300011
Image credits: blu3ant
Image credits: Brvfan
Image credits: greendrtstories
Image credits: realMichaelPat
Image credits: GetSmartResist
Image credits: AtmaSinnan
"Bake like an Egyptian" ... wait, are you sure this is the correct song?
I know I'm going to be singing THAT for hours now.
Load More Replies...Oh dear, I just know he's awakened some ancient evil that's going to come alive as soon as it makes contact with roast beef.
The Egyptians were right. Bury it deep down and it will come alive again. It is just a shame they weren't right about the species. Joking aside, I wish I could have been there to taste the bread.
This is plain amazing !! This should in international news and journals for all its worth !!!!!!!Felling very grateful foor Bored Panda to share this break-through.
"Bake like an Egyptian" ... wait, are you sure this is the correct song?
I know I'm going to be singing THAT for hours now.
Load More Replies...Oh dear, I just know he's awakened some ancient evil that's going to come alive as soon as it makes contact with roast beef.
The Egyptians were right. Bury it deep down and it will come alive again. It is just a shame they weren't right about the species. Joking aside, I wish I could have been there to taste the bread.
This is plain amazing !! This should in international news and journals for all its worth !!!!!!!Felling very grateful foor Bored Panda to share this break-through.

240
40